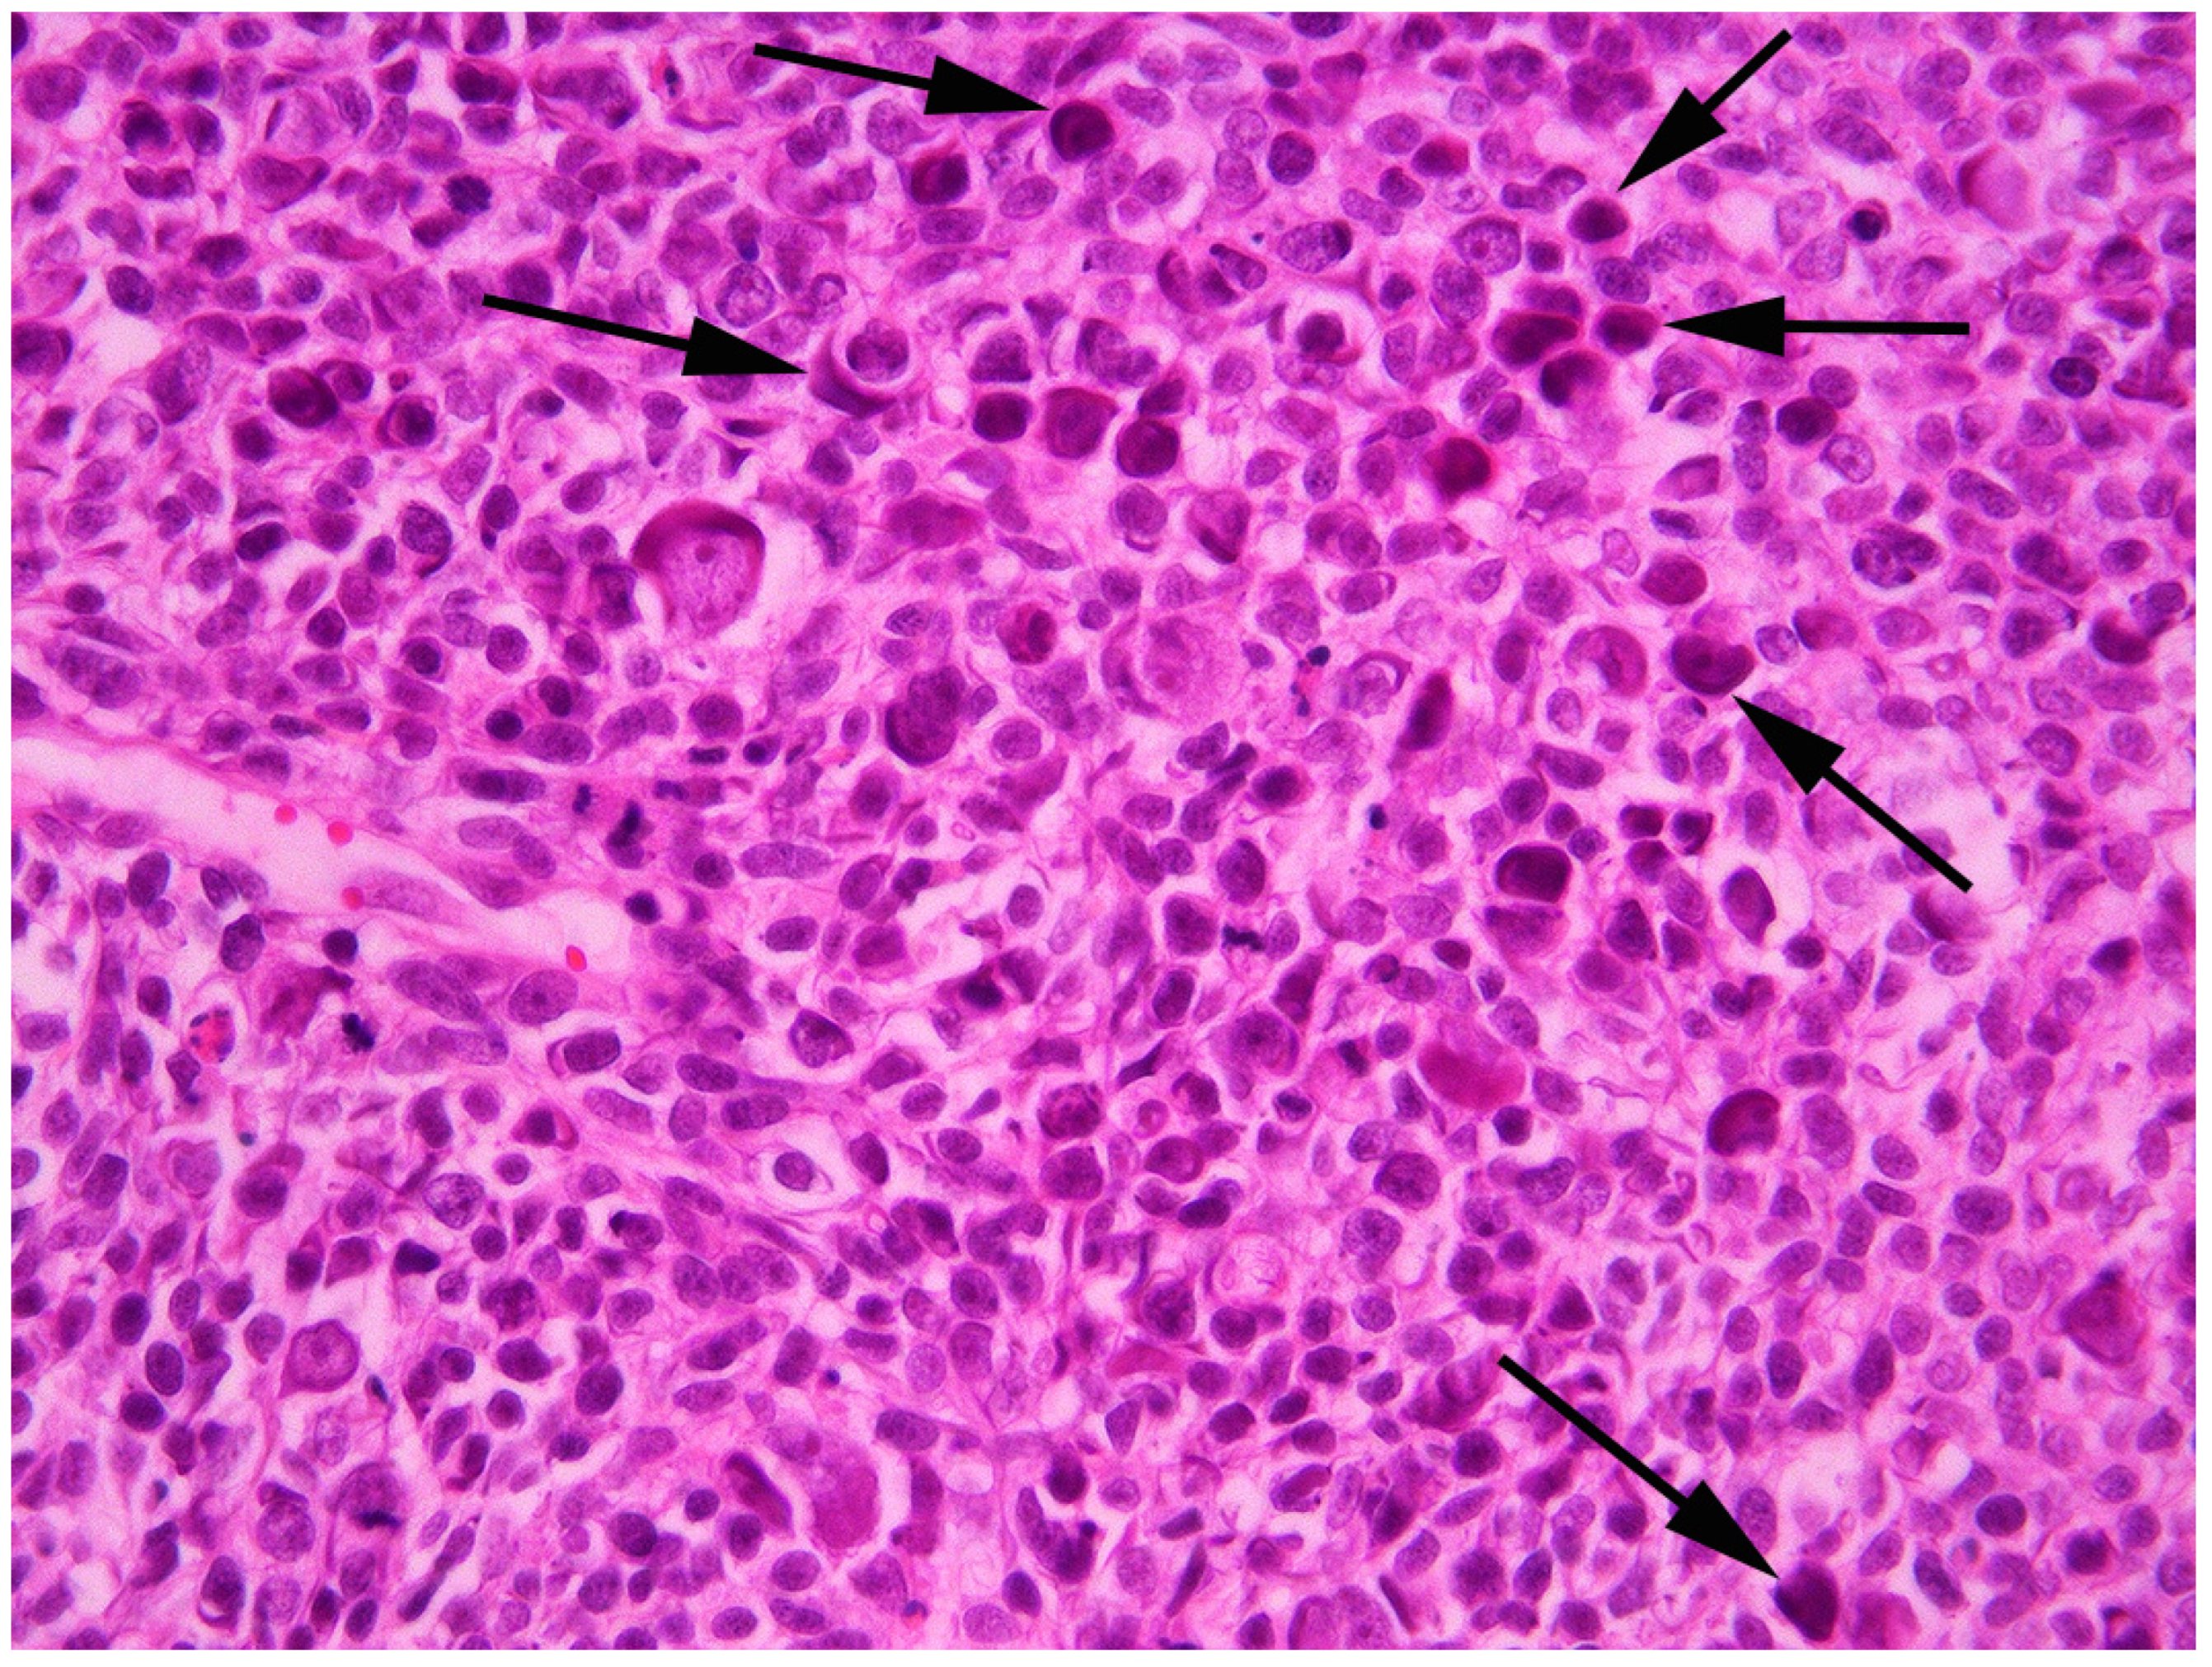
Vetsci 09 00671 g003 Vetsci 09 00671 g003

Detection of a Novel Papillomavirus Type within a Feline Cutaneous Basal Cell Carcinoma
Abstract
Simple Summary
Abstract
1. Introduction
2. Case Presentation and Diagnosis
3. Discussion
4. Conclusions
Author Contributions
Funding
Institutional Review Board Statement
Informed Consent Statement
Data Availability Statement
Conflicts of Interest
References
- Munday, J.S.; Knight, C.G.; Luff, J.A. Papillomaviral skin diseases of humans, dogs, cats and horses: A comparative review. Part 1: Papillomavirus biology and hyperplastic lesions. Vet. J. 2022, 288, 105897. [Google Scholar] [CrossRef]
- Munday, J.S.; Knight, C.G.; Luff, J.A. Papillomaviral skin diseases of humans, dogs, cats and horses: A comparative review. Part 2: Pre-neoplastic and neoplastic diseases. Vet. J. 2022, 288, 105898. [Google Scholar] [CrossRef] [PubMed]
- Plummer, M.; de Martel, C.; Vignat, J.; Ferlay, J.; Bray, F.; Franceschi, S. Global burden of cancers attributable to infections in 2012: A synthetic analysis. Lancet Glob. Health 2016, 4, e609–e616. [Google Scholar] [CrossRef] [PubMed]
- Bernard, H.U.; Burk, R.D.; Chen, Z.; van Doorslaer, K.; Hausen, H.; de Villiers, E.M. Classification of papillomaviruses (PVs) based on 189 PV types and proposal of taxonomic amendments. Virology 2010, 401, 70–79. [Google Scholar] [CrossRef] [PubMed]
- Munday, J.S.; Thomson, N.A. Papillomaviruses in Domestic Cats. Viruses 2021, 13, 1664. [Google Scholar] [CrossRef] [PubMed]
- Altamura, G.; Corteggio, A.; Pacini, L.; Conte, A.; Pierantoni, G.M.; Tommasino, M.; Accardi, R.; Borzacchiello, G. Transforming properties of Felis catus papillomavirus type 2 E6 and E7 putative oncogenes in vitro and their transcriptional activity in feline squamous cell carcinoma in vivo. Virology 2016, 496, 1–8. [Google Scholar] [CrossRef]
- Hoggard, N.; Munday, J.S.; Luff, J. Localization of Felis catus papillomavirus type 2 E6 and E7 RNA in feline cutaneous squamous cell carcinoma. Vet. Pathol. 2018, 55, 409–416. [Google Scholar] [CrossRef]
- Lange, C.E.; Tobler, K.; Markau, T.; Alhaidari, Z.; Bornand, V.; Stockli, R.; Trussel, M.; Ackermann, M.; Favrot, C. Sequence and classification of FdPV2, a papillomavirus isolated from feline Bowenoid in situ carcinomas. Vet. Microbiol. 2009, 137, 60–65. [Google Scholar] [CrossRef]
- Munday, J.S.; Gibson, I.; French, A.F. Papillomaviral DNA and increased p16CDKN2A protein are frequently present within feline cutaneous squamous cell carcinomas in ultraviolet-protected skin. Vet. Dermatol. 2011, 22, 360–366. [Google Scholar] [CrossRef]
- Thomson, N.A.; Munday, J.S.; Dittmer, K.E. Frequent detection of transcriptionally active Felis catus papillomavirus 2 in feline cutaneous squamous cell carcinomas. J. Gen. Virol. 2016, 97, 1189–1197. [Google Scholar] [CrossRef]
- Ito, S.; Chambers, J.K.; Sumi, A.; Yamashita-Kawanishi, N.; Omachi, T.; Haga, T.; Nakayama, H.; Uchida, K. Involvement of Felis catus papillomavirus type 2 in the tumorigenesis of feline Merkel cell carcinoma. Vet. Pathol. 2022, 59, 63–74. [Google Scholar] [CrossRef] [PubMed]
- Yamashita-Kawanishi, N.; Sawanobori, R.; Matsumiya, K.; Uema, A.; Chambers, J.K.; Uchida, K.; Shimakura, H.; Tsuzuki, M.; Chang, C.Y.; Chang, H.W.; et al. Detection of Felis catus papillomavirus type 3 and 4 DNA from squamous cell carcinoma cases of cats in Japan. J. Vet. Med. Sci. 2018, 80, 1236–1240. [Google Scholar] [CrossRef] [PubMed]
- Carrai, M.; Van Brussel, K.; Shi, M.; Li, C.X.; Chang, W.S.; Munday, J.S.; Voss, K.; McLuckie, A.; Taylor, D.; Laws, A.; et al. Identification of a novel papillomavirus associated with squamous cell carcinoma in a domestic cat. Viruses 2020, 12, 124. [Google Scholar] [CrossRef] [PubMed]
- Munday, J.S.; Fairley, R.A.; Mills, H.; Kiupel, M.; Vaatstra, B.L. Oral papillomas associated with Felis catus papillomavirus type 1 in 2 domestic cats. Vet. Pathol. 2015, 52, 1187–1190. [Google Scholar] [CrossRef] [PubMed]
- Munday, J.S.; Peters-Kennedy, J. Consistent detection of Felis domesticus papillomavirus 2 DNA sequences within feline viral plaques. J. Vet. Diagn. Investig. 2010, 22, 946–949. [Google Scholar] [CrossRef] [PubMed]
- Munday, J.S.; Marshall, S.; Thomson, N.A.; Kiupel, M.; Heathcott, R.W.; French, A. Multiple viral plaques with sebaceous differentiation associated with an unclassified papillomavirus type in a cat. NZ Vet. J. 2017, 65, 219–223. [Google Scholar] [CrossRef]
- Dunowska, M.; Munday, J.S.; Laurie, R.E.; Hills, S.F. Genomic characterisation of Felis catus papillomavirus 4, a novel papillomavirus detected in the oral cavity of a domestic cat. Virus Genes 2014, 48, 111–119. [Google Scholar] [CrossRef]
- Munday, J.S.; Lam, A.T.H.; Sakai, M. Extensive progressive pigmented viral plaques in a Chihuahua dog. Vet. Dermatol. 2022, 33, 252–254. [Google Scholar] [CrossRef]
- Munday, J.S.; French, A.; Thomson, N. Detection of DNA sequences from a novel papillomavirus in a feline basal cell carcinoma. Vet. Dermatol. 2017, 28, e236–e260. [Google Scholar] [CrossRef]
- Goldschmidt, M.H.; Munday, J.S.; Scruggs, J.L.; Klopfleisch, R.; Kiupel, M. Epithelial Tumors of the Skin; Davis-Thomson Foundation: Gurnee, IL, USA, 2018. [Google Scholar]
- van der Steen, F.; Grinwis, G.C.M.; Weerts, E.; Teske, E. Feline and canine Merkel cell carcinoma: A case series and discussion on cellular origin. Vet. Comp. Oncol. 2021, 19, 393–398. [Google Scholar] [CrossRef]
- Gross, T.L.; Ihrke, P.J.; Walder, E.J.; Affolter, V.K. Skin Diseases of the Dog and Cat: Clinical and Histopathologic Diagnosis, 2nd ed.; Blackwell Science: Oxford, UK, 2005; pp. 571–574. [Google Scholar]
- Thomson, N.A.; Dunowska, M.; Munday, J.S. The use of quantitative PCR to detect Felis catus papillomavirus type 2 DNA from a high proportion of queens and their kittens. Vet. Microbiol. 2015, 175, 211–217. [Google Scholar] [CrossRef] [PubMed]
- Munday, J.S.; Kiupel, M.; French, A.F.; Howe, L.; Squires, R.A. Detection of papillomaviral sequences in feline Bowenoid in situ carcinoma using consensus primers. Vet. Dermatol. 2007, 18, 241–245. [Google Scholar] [CrossRef] [PubMed]
- O’Neill, S.H.; Newkirk, K.M.; Anis, E.A.; Brahmbhatt, R.; Frank, L.A.; Kania, S.A. Detection of human papillomavirus DNA in feline premalignant and invasive squamous cell carcinoma. Vet. Dermatol. 2011, 22, 68–74. [Google Scholar] [CrossRef] [PubMed]

Publisher’s Note: MDPI stays neutral with regard to jurisdictional claims in published maps and institutional affiliations. |
© 2022 by the authors. Licensee MDPI, Basel, Switzerland. This article is an open access article distributed under the terms and conditions of the Creative Commons Attribution (CC BY) license (https://creativecommons.org/licenses/by/4.0/).
Share and Cite
Munday, J.S.; Hunt, H.; Orbell, G.; Pfeffer, H. Detection of a Novel Papillomavirus Type within a Feline Cutaneous Basal Cell Carcinoma. Vet. Sci. 2022, 9, 671. https://doi.org/10.3390/vetsci9120671
Munday JS, Hunt H, Orbell G, Pfeffer H. Detection of a Novel Papillomavirus Type within a Feline Cutaneous Basal Cell Carcinoma. Veterinary Sciences. 2022; 9(12):671. https://doi.org/10.3390/vetsci9120671
Chicago/Turabian StyleMunday, John S., Hayley Hunt, Geoff Orbell, and Hayley Pfeffer. 2022. "Detection of a Novel Papillomavirus Type within a Feline Cutaneous Basal Cell Carcinoma" Veterinary Sciences 9, no. 12: 671. https://doi.org/10.3390/vetsci9120671
APA StyleMunday, J. S., Hunt, H., Orbell, G., & Pfeffer, H. (2022). Detection of a Novel Papillomavirus Type within a Feline Cutaneous Basal Cell Carcinoma. Veterinary Sciences, 9(12), 671. https://doi.org/10.3390/vetsci9120671





